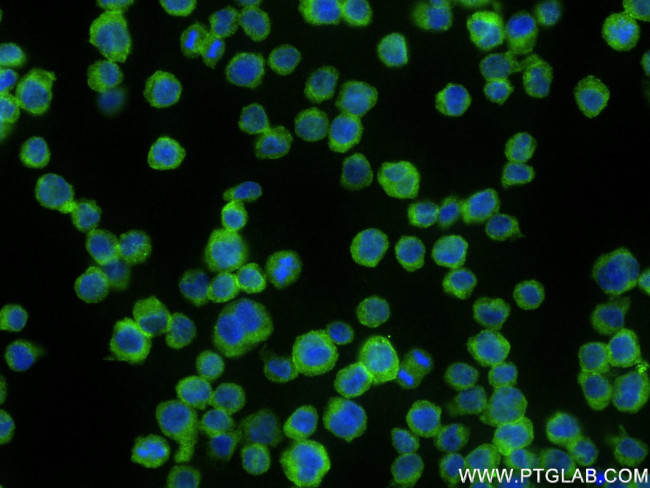
NLRC5 Antibody in Immunocytochemistry (ICC/IF)
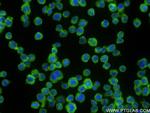
NLRC5 Antibody in Immunocytochemistry (ICC/IF)

Search
Proteintech
NLRC5 Recombinant Rabbit Monoclonal Antibody (240338D8)
{{$productOrderCtrl.translations['antibody.pdp.commerceCard.promotion.promotions']}}
{{$productOrderCtrl.translations['antibody.pdp.commerceCard.promotion.viewpromo']}}
{{$productOrderCtrl.translations['antibody.pdp.commerceCard.promotion.promocode']}}: {{promo.promoCode}} {{promo.promoTitle}} {{promo.promoDescription}}. {{$productOrderCtrl.translations['antibody.pdp.commerceCard.promotion.learnmore']}}
产品信息
83384-2-RR
种属反应
宿主/亚型
Expression System
分类
类型
克隆号
抗原
偶联物
形式
浓度
规格
纯化类型
保存液
内含物
保存条件
运输条件
产品详细信息
Immunogen sequence: MDPVGLQLGN KNLWSCLVRL LTKDPEWLNA KMKFFLPNTD LDSRNETLDP EQRVILQLNK LHVQGSDTWQ SFIHCVCMQL EVPLDLEVLL LSTFGYDDGF TSQLGAEGKS QPESQLHHGL KRPHQSCGSS PRRKQCKKQQ LELAKKYLQL LRTSAQQRYR
靶标信息
NOD4 is a member of the NOD (nucleotide-binding oligomerization domain) family, a group of proteins that are involved in innate immune defense. NOD4 contains a CARD-like domain, a central NOD domain and a large LRR region. NOD4, an IFN-gamma-inducible nuclear protein, plays a role in homeostatic control of innate immunity and in antiviral defense mechanisms. As a key negative regulator of NF-kappa-B and type I interferon signaling, NOD4 may be a useful target for manipulating immune responses against infectious or inflammation-associated diseases, including cancer.
仅用于科研。不用于诊断过程。未经明确授权不得转售。
篇参考文献 (0)
生物信息学
蛋白别名: Caterpiller protein 16.1; CLR16.1; NLR member; NOD family member; NOD-like receptor C5; Nucleotide-binding oligomerization domain protein 27; Nucleotide-binding oligomerization domain protein 4; nucleotide-binding oligomerization domain, leucine rich repeat and CARD domain containing 5; nucleotide-binding oligomerization domains 27; Protein NLRC5; unnamed protein product
基因别名: CLR16.1; NLRC5; NOD27; NOD4
UniProt ID: (Human) Q86WI3
Entrez Gene ID: (Human) 84166